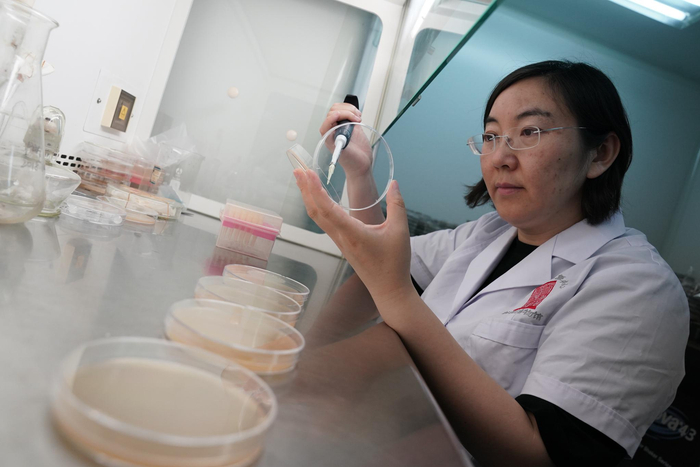
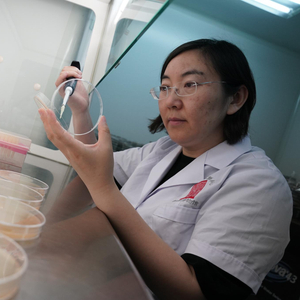

原标题:首都博物馆地下,一副明代描金彩绘漆棺“复活”了!
首都博物馆办公区三层,生物实验室内,研究员闫丽正手持仪器,对着几个装着土的培养皿进行检测。这是在为即将开展的“万年永宝:中国馆藏文物保护成果展”中一件“借调”文物做进馆检测。
这里是首博文物保护修复中心,首都的“文物医院”。这间文物医院里,有一支平均年龄30多岁的年轻团队,35位文物医生涵盖化学、生物、材料、文物保护、地质、科技史等多个专业方向。在保护修复馆藏文物同时,他们每年还要为各地文保单位提供技术支撑、修复协助。
国际博物馆日到来之际,记者走进这间文物医院,探秘文物医生如何运用传统技艺和科技手段,为千年文物问诊治疗,保护文物健康。
为新展文物“体检”微生物
闫丽面前,几个培养皿里的土,来自一件河北行唐故郡东周遗址出土的车轮遗迹。“这是消杀前的土,这是消杀后的土,仔细看这个,里面还有几个小虫子……”闫丽依次指着几个培养皿,耐心地解释,这件车轮遗迹刚刚运至首博时,打开存放文物的包装,工作人员们发现,除了镶嵌在车轮周边和缝隙中的土,车轮表面还有一些白色的痕迹。
这些痕迹是不是霉菌?土里还有哪些微生物?“让土进展厅,对我们来说还是第一次。因为土是微生物的主要来源,文物要在展厅中展出3个月,必须先给它做个‘体检’,检测一下土里的微生物情况。”她说。
作为微生物硕士,这是闫丽专长的领域。“第一次去取样时,我发现土质比较湿润,环境太湿的话,上面容易长毛,太干的话,又怕车轮干裂。”闫丽说,她对土和白色痕迹分别取了样,“预防性保护组的邵芳老师请专家对土质进行了消杀处理,消杀后,我再取一次样,对比两次检测结果。”对白色痕迹的监测结果显示,这些其实是结晶盐,不会对微生物环境造成影响。等检测结果全部出来之后,会形成一份“体检报告”,这件文物就可以放心进馆展出。
除了日常工作中的检测,闫丽和同事们还承担了生物实验室的科研课题。
一张工作台上,一摞摞的培养皿里,养着各种各样的霉菌。“我经常要和它们打交道。”闫丽笑盈盈地说。2006年来到刚刚落成的首博新馆,她就跟着纺织品和书画组的师傅学习,如何将所学融入到文物修复?耳濡目染间,她慢慢摸到了门道儿。比如,有些丝织文物由于尸体腐烂等原因,表面会被血渍等污染,去除难度很大,闫丽就从生物酶的角度入手,反复实验,培养微生物清洗污渍,最终找到一种微生物,仅仅进行几分钟的无动力浸泡,血渍就会消除,这表明微生物清洗文物不仅可行,而且高效。
她和同事还创新发明出一种生物酶揭展古书画技术,解决了困扰书画修复的百年难题。“古人作画的宣纸叫画心,命纸是为了保护而裱在画心背后的一层或多层纸,每层之间用淀粉制的浆糊胶粘。后世想修画,多是用水闷,再手搓揭开命纸。稍不留神,揭多了,画心纸少半层,画意缺失;揭少了,重新装裱卷收后,残留物质会硌伤画心。”闫丽解释说,通过生物酶降解浆糊,仅用如绒毛划过手心般触感的力度,便可以轻易揭开古画,使画心完好无损,简单而安全。
“这些技术都是服务于传统修复的,传统组的老师们遇到哪些难题,我们就会利用科技的手段,想办法帮他们解决。”闫丽说。
科技手段诊断“青铜病”
五层青铜杂项修复组办公室里,修复师倪炎取来一件刚刚修复完成的元代方鼎。“这是我们馆藏的一件文物,刚送来的时候,就是断了一条腿。按照传统的修复方法,我们只需要用金属锡对它进行焊接,再按照修旧如旧的原则再对它进行手工补旧。”倪炎说,现在有了科技手段加持,我们在正式“治病”之前,都要先给文物做一个全方位的“体检”——其中,X射线探伤相当于“透视”,了解文物的内部结构,检查文物内部有没有断裂;X射线荧光分析用于检测文物的金属成分;X射线衍射,则可以检测青铜器的锈蚀产物。

利用这些科技手段对方鼎进行全面“体检”后,一份健康报告形成。倪炎和同事们在报告中发现了氯这一元素,“这表明,这件器物患了‘青铜病’。”倪炎解释,以往专家们鉴定“青铜病”的方法就是凭肉眼看,“这种锈呈浅绿色的粉末状,疏松膨胀,会像瘟疫一样在青铜器中传播和蔓延,腐蚀铜的本质。”然而这件器物的表面只呈现出蓝绿色、黑色和黄色,这些锈蚀都是无害的。倪炎和同事们用仪器对方鼎的多个部位进行检测,均发现了氯元素,“我们推断,‘青铜病’的锈层藏得更深,被表面的锈蚀给盖住了。”
诊断出来了,如何治疗?“这就需要用到它——超声波清洗机。”倪炎指着办公室里一个“大箱子”说,“我们把方鼎放在里面,用脱氯的药水给方鼎‘洗个澡’,通过超声波震动进行脱氯处理。洗完澡后,我们还要把方鼎送去实验室检测,直至完全检测不出氯元素。”
之后,再按照传统修复方法对方鼎的短腿进行锡焊,再进行调色、补配,用工具一点点进行手工补旧,涂上缓蚀剂和封覆剂作为“保护层”,经过一个多月的时间,方鼎修复完成。“别看我们这里跟工厂似的,用传统修复技艺修复文物,就需要我们特别细致、耐心了。”倪炎随手一指,一排抽屉上贴着字条,分别写着磨头、钻头、锉刀、毛笔、刷子、刻刀、手术刀、镊子等,这些刻花纹的工具都是他们自己做的。“这些个老手艺,都是13年前我当学徒时,师傅口口相传的,留下的文字资料很少。”
当年的小学徒,如今已成长为组里的负责人,“对我来说,和一件件文物打交道,就像亲手触摸到一段段历史。”倪炎说,他很高兴,用自己传承下来的老手艺可以和先进科技手段结合,为更多饱经风霜的文物祛病诊疗。
抢救性保护“百病缠身”漆棺
首博办公区地下一层,考古实验室一间玻璃房子里,何秋菊和同事身着防护服,戴着口罩、手套、帽子,“全副武装”的她们正在修复一件长期“住院”的重要文物——明嘉靖年间考古出土的一具明代朱漆地描金彩绘漆棺。
面前的漆棺,长度约2.4米、宽1米,高0.9米左右,色彩鲜艳,仔细看,漆棺上绘制精美的漆画。“漆棺两侧主画面有完整的描金漆画,共出现人物形象200余人,包括官员、仆役、僧人、小贩、乐队、杂耍者、接引仙人等,还有马匹、树木、轿辇、房屋、流云、山峦等景物,绘画技艺精湛,人物形象生动。”何秋菊说,4年前,她第一次见到这件文物时,则是另一番样貌。
2017年8月,石景山区五里坨一个建筑工地意外发现一座石室墓葬。根据墓志铭记载,墓主人为明代嘉靖三十八年(公元1559年)内官监太监。专家鉴定,漆棺上绘制的精美漆画,具有极高的艺术研究价值。2017年底,漆棺整体运至首博进行抢救性保护。
“打开外椁板后,漆棺呈现在大家眼前。”何秋菊仍记得这件漆棺第一次亮相实验室的场景,“漆棺四面有描金彩绘,保存较完整,色彩鲜艳,漆面有较强的反光感。美轮美奂的漆画,却百病缠身——霉菌滋生,植物根系繁衍,木胎糟朽,漆皮起翘、脱落等数种病害,严重影响漆画安全。”
专家团队采用了多种科技手段对漆棺进行“体检”。“我们采用了 X光探伤,诊断它内部的结构,还采用了一些高科技的手段,比如说拉曼光谱,包括气相色谱质谱联用这些方法,来对漆棺的材料制作材料和工艺进行一些研究。”何秋菊说,这具漆棺属于典型的北方地区出土的半饱水漆木器,保护方法有别于南方饱水漆木器。由于此类出土文物的保护修复工作在国内尚无成功先例可循,需要边探索、边推进,有相当的难度和挑战性。
“漆棺重见天日,从阴暗潮湿、低温的环境,突然展现在大家的面前,所有环境突然被打破,是它最脆弱的时候,因此建立一个与地下比较类似的环境尤为重要。”何秋菊说,为此,首博紧急召开了专家会议,最终决定采取临时搭建一个气密帐存放漆棺,“建立模拟墓室内的低温高湿环境,两年后改建了玻璃房,通过缓慢降低湿度对漆棺进行荫干法脱水处理。目前,漆棺的木材含水率在严密监测下缓慢下降,漆棺尺寸未发生改变。”
随着氧气含量突增,温度适宜,休眠的霉菌虫害重新滋生繁衍。这是修复团队面临的又一个难题。在木材防霉专家的指导下,何秋菊和同事用棉签和脱脂棉球一点一点清理表面的霉菌,给漆棺“打点滴”,将抑菌药物输入内部,进行彻底的防霉处理。解决了防霉问题后,漆棺上蔓延的植物根系又为修复团队出了难题。“这些根系遮盖了漆画,而且受潮膨胀后又随时影响漆画的安全。通过危害性评估,我们找到了一个比较稳妥的方法:用镊子、手术刀把露出表面的根系,一点点地、像动手术一样地取出来。”何秋菊说,团队用了2年时间清除植物根系,最后清出的根系有满满两大箱。

回贴漆皮是何秋菊和同事遇到的最大的困难。“脱落的漆皮有几百块,每一块呈5层,5层加起来都不到0.5毫米,会逐层起翘,需要我们一层一层地贴回去。用小镊子碰一下,可能就破碎成好几片了。”何秋菊说,大多数化学胶粘剂在低温高湿环境下不干燥,给漆皮的回贴增添难度,“因此,我们回归到大漆传统技艺,采用原材料进行修复,目前,漆皮加固回贴部位没有起翘脱落现象,古人智慧得到了最大程度传承。”
目前,何秋菊和同事正在进行的工作是用生漆加木屑对漆棺进行裂隙填补,接下来还要完成一系列保护修复工作,逐步降低环境湿度,缓慢脱水,定期监测木胎含水率及裂隙的变形情况,最后进行脱水完成后的修复。整个过程下来,还需要3年左右。
长期与大漆接触,何秋菊的手腕上因过敏长出了漆疮,她却不在乎。“我们这些文物医生,就是要利用一切可以利用的材料、技术方法延缓文物的寿命。”她说。
在这座博物馆,科技在文博领域的“跨界”故事每天都在上演。文物医生们伏案埋首,妙手还原着历史的绚烂,传承文明璀璨。